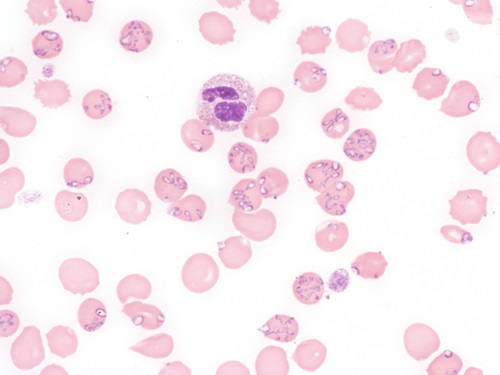

Here’s some news that literally sucks: tickborne maladies such as Lyme disease, and now babesiosis, are becoming more prevalent. ColumbiaDoctors.org (an affiliate of Columbia University) warns that babesiosis in particular is cause for concern for those in the Northeast and Midwest because the disease is becoming more entrenched, marching further north into areas not previously considered babesiosis territory. A March 2023 report from the CDC highlighted a significant increase in the Northeast of cases of babesiosis, a disease caused by parasites transmitted by the blacklegged tick, and found that babesiosis has gained a foothold in 10 states in the Northeast and Midwest.
When asked why we’re just hearing about babesiosis now, Santiago Sanchez-Vicente, PhD, an associate research scientist in the Center for Infection and Immunity at Columbia’s Mailman School of Public Health who studies tick-borne diseases such as babesiosis, notes, “It’s been endemic in parts of the Northeast and Midwest for almost 50 years, but it hasn’t been very common. The new report shows that babesiosis cases significantly increased in Northeastern states where the disease has been endemic. And case rates in three other states where the disease was not considered endemic (Maine, Vermont and New Hampshire) are now similar to, or higher than, rates in the endemic states.”
Sanchez-Vicente points to climate change as a primary factor that has led to the geographic expansion of every tick species further north. The higher temperatures and milder winters prolong the life cycle of the tick, so they remain active year-round. The tick population is higher now than ever before.
“The incidence of babesiosis has increased exponentially in the U.S. Northeast from 2011 to 2019, particularly in Maine, New Hampshire and Vermont,” concurs the Association for the Advancement of Blood & Biotherapies (AABB). “Vermont experienced a 1,602 percent increase in cases from 2011 to 2019, up from two cases in 2011 to 34 in 2019. In Maine, the number of new cases jumped from nine cases in 2011 to 138 cases in 2019, a 1,422 percent rate increase. Reported new cases in New Hampshire increased by 372 percent, up from 13 to 63.” Overall, more than 16,000 cases of babesiosis were reported to the CDC between 2011 and 2019.
“The incidence of babesiosis has increased exponentially in the U.S. Northeast from 2011 to 2019, particularly in Maine, New Hampshire and Vermont,” concurs the Association for the Advancement of Blood & Biotherapies (AABB). “Vermont experienced a 1,602 percent increase in cases from 2011 to 2019, up from two cases in 2011 to 34 in 2019. In Maine, the number of new cases jumped from nine cases in 2011 to 138 cases in 2019, a 1,422 percent rate increase. Reported new cases in New Hampshire increased by 372 percent, up from 13 to 63.” Overall, more than 16,000 cases of babesiosis were reported to the CDC between 2011 and 2019.
ColumbiaDoctors.org explains that while Lyme disease is caused by a bacterial infection, babesiosis is caused by a parasite that infects red blood cells. Symptoms of babesiosis are non-specific and include fever, muscle and joint pain, and headache. “When red blood cells carrying the parasite travel through the spleen, the organ detects the abnormal red blood cells and produces macrophages that attack them. But in people who do not have a spleen or who are immunocompromised, the body can’t muster the appropriate immune response. In these cases, the disease can be very severe, even fatal. In fact, babesiosis is fatal in between 2 percent and 9 percent of those who require hospitalization, whereas Lyme disease is not fatal.”
Moreover, the CDC cautions that the increasing prevalence of babesiosis could pose risks to the blood supply. The disease is transmissible through blood transfusion, and infections acquired this way have shown to have significantly worse outcomes and higher risk of death than those acquired through a tick bite. The US Food and Drug Administration currently recommends blood donations screening for babesiosis in 14 states and Washington, DC, in and around areas where transmission is endemic.
As it happens, the blacklegged tick is also responsible for transmitting anaplasmosis, which fortunately is not fatal. The same antibiotic used to treat Lyme disease will also treat anaplasmosis if co-infection occurs. Additionally, blacklegged ticks carry microbes that can cause Powassan disease and Borrelia miyamotoi disease. The diseases are usually transmitted by female adult ticks or nymphs, which are about the size of a poppy seed, within 36 to 48 hours after being bitten, though the Powassan virus can be transmitted as soon as 15 minutes after a tick attaches to the skin.
And then there’s ehrlichiosis, which comes courtesy of the lone star tick. The species also carries microbes that cause tularemia, Heartland virus and Bourbon virus. “Forty years ago, there were no lone star ticks in the Northeast. Now it’s everywhere,” warns ColumbiaDoctors.org. “It’s found as far north as Maine and Canada and is now the most abundant tick in Long Island. The blacklegged tick stays in the vegetation and will only attach itself to you if you pass through the bushes. But the lone star tick is very aggressive and will crawl onto you if you are nearby but not touching the vegetation.”
 The American dog tick, though less abundant in the Northeast than it was several years ago, carries bacteria that can cause tularemia and Rocky Mountain spotted fever. This tick is much larger than the blacklegged tick; when engorged with blood, female dog ticks are about the size of a grape, informs ColumbiaDoctors.org.
The American dog tick, though less abundant in the Northeast than it was several years ago, carries bacteria that can cause tularemia and Rocky Mountain spotted fever. This tick is much larger than the blacklegged tick; when engorged with blood, female dog ticks are about the size of a grape, informs ColumbiaDoctors.org.
For those hosting outdoor events, particularly in the Northeast and Midwest, awareness and prevention are key. Most cases of babesiosis occur from late spring through early autumn.
“Practice tick bite prevention, including wearing long pants, avoiding underbrush and long grass, and using tick repellents,” according to the CDC. To remove a tick, use fine-tipped tweezers to grasp the tick as close to the skin’s surface as possible. Pull upward with steady, even pressure. Don’t twist or jerk the tick, as this can cause the mouth-parts to break off and remain in the skin. Clean the bite area with rubbing alcohol or soap and water.

